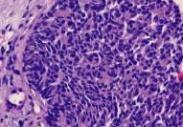

-
福克斯-阜太斯病
628健康網為您分享有關福克斯-阜太斯病的癥狀,福克斯-阜太斯病的治療方法,福克斯-阜太斯病的預防知識,福克斯-阜太斯病的...
-
慢性細菌性前列腺炎
628健康網為您分享有關慢性細菌性前列腺炎的癥狀,慢性細菌性前列腺炎的治療方法,慢性細菌性前列腺炎的預防知識,慢性細菌...
-
梅克爾細胞癌
628健康網為您分享有關梅克爾細胞癌的癥狀,梅克爾細胞癌的治療方法,梅克爾細胞癌的預防知識,梅克爾細胞癌的癥狀圖片,梅...
-
結腸類癌
628健康網為您分享有關結腸類癌的癥狀,結腸類癌的治療方法,結腸類癌的預防知識,結腸類癌的癥狀圖片,結腸類癌吃什么藥,結...
-
小兒史-約綜合征
628健康網為您分享有關小兒史-約綜合征的癥狀,小兒史-約綜合征的治療方法,小兒史-約綜合征的預防知識,小兒史-約綜合征的...
-
酒渣鼻
628健康網為您分享有關酒渣鼻的癥狀,酒渣鼻的治療方法,酒渣鼻的預防知識,酒渣鼻的癥狀圖片,酒渣鼻吃什么藥,酒渣鼻怎么治...
-
性欲亢進
628健康網為您分享有關性欲亢進的癥狀,性欲亢進的治療方法,性欲亢進的預防知識,性欲亢進的癥狀圖片,性欲亢進吃什么藥,性...
-
成人癢疹
628健康網為您分享有關成人癢疹的癥狀,成人癢疹的治療方法,成人癢疹的預防知識,成人癢疹的癥狀圖片,成人癢疹吃什么藥,成...
-
冬季瘙癢癥
628健康網為您分享有關冬季瘙癢癥的癥狀,冬季瘙癢癥的治療方法,冬季瘙癢癥的預防知識,冬季瘙癢癥的癥狀圖片,冬季瘙癢癥...
-
惡性黑素瘤
628健康網為您分享有關惡性黑素瘤的癥狀,惡性黑素瘤的治療方法,惡性黑素瘤的預防知識,惡性黑素瘤的癥狀圖片,惡性黑素瘤...
-
營養代謝障礙疾病
628健康網為您分享有關營養代謝障礙疾病的癥狀,營養代謝障礙疾病的治療方法,營養代謝障礙疾病的預防知識,營養代謝障礙疾...
-
急性化膿性鼻竇炎
628健康網為您分享有關急性化膿性鼻竇炎的癥狀,急性化膿性鼻竇炎的治療方法,急性化膿性鼻竇炎的預防知識,急性化膿性鼻竇...
-
持續性肢皮炎
628健康網為您分享有關持續性肢皮炎的癥狀,持續性肢皮炎的治療方法,持續性肢皮炎的預防知識,持續性肢皮炎的癥狀圖片,持...
-
噪聲病
628健康網為您分享有關噪聲病的癥狀,噪聲病的治療方法,噪聲病的預防知識,噪聲病的癥狀圖片,噪聲病吃什么藥,噪聲病怎么治...
-
甲狀腺腫大
628健康網為您分享有關甲狀腺腫大的癥狀,甲狀腺腫大的治療方法,甲狀腺腫大的預防知識,甲狀腺腫大的癥狀圖片,甲狀腺腫大...
-
轉移性皮膚鈣化病
628健康網為您分享有關轉移性皮膚鈣化病的癥狀,轉移性皮膚鈣化病的治療方法,轉移性皮膚鈣化病的預防知識,轉移性皮膚鈣化...
-
妊娠合并巨細胞病毒感染
628健康網為您分享有關妊娠合并巨細胞病毒感染的癥狀,妊娠合并巨細胞病毒感染的治療方法,妊娠合并巨細胞病毒感染的預防...
-
小兒尿崩癥
628健康網為您分享有關小兒尿崩癥的癥狀,小兒尿崩癥的治療方法,小兒尿崩癥的預防知識,小兒尿崩癥的癥狀圖片,小兒尿崩癥...
-
鼻出血
628健康網為您分享有關鼻出血的癥狀,鼻出血的治療方法,鼻出血的預防知識,鼻出血的癥狀圖片,鼻出血吃什么藥,鼻出血怎么治...
-
包皮龜頭炎
628健康網為您分享有關包皮龜頭炎的癥狀,包皮龜頭炎的治療方法,包皮龜頭炎的預防知識,包皮龜頭炎的癥狀圖片,包皮龜頭炎...
-
慢性皮膚粘膜念珠菌病
628健康網為您分享有關慢性皮膚粘膜念珠菌病的癥狀,慢性皮膚粘膜念珠菌病的治療方法,慢性皮膚粘膜念珠菌病的預防知識...
-
濕疹
628健康網為您分享有關濕疹的癥狀,濕疹的治療方法,濕疹的預防知識,濕疹的癥狀圖片,濕疹吃什么藥,濕疹怎么治療,濕疹患者食...
-
原發性腎上腺皮質功能減退癥
628健康網為您分享有關原發性腎上腺皮質功能減退癥的癥狀,原發性腎上腺皮質功能減退癥的治療方法,原發性腎上腺皮質功能...
-
黃褐斑
628健康網為您分享有關黃褐斑的癥狀,黃褐斑的治療方法,黃褐斑的預防知識,黃褐斑的癥狀圖片,黃褐斑吃什么藥,黃褐斑怎么治...
-
原發性系統性淀粉樣變
628健康網為您分享有關原發性系統性淀粉樣變的癥狀,原發性系統性淀粉樣變的治療方法,原發性系統性淀粉樣變的預防知識...
-
亞臨床甲狀腺功能亢進
628健康網為您分享有關亞臨床甲狀腺功能亢進的癥狀,亞臨床甲狀腺功能亢進的治療方法,亞臨床甲狀腺功能亢進的預防知識...
-
陰囊濕疹
628健康網為您分享有關陰囊濕疹的癥狀,陰囊濕疹的治療方法,陰囊濕疹的預防知識,陰囊濕疹的癥狀圖片,陰囊濕疹吃什么藥,陰...
-
早熟性兒童乳房肥大癥
628健康網為您分享有關早熟性兒童乳房肥大癥的癥狀,早熟性兒童乳房肥大癥的治療方法,早熟性兒童乳房肥大癥的預防知識...
-
亞健康
628健康網為您分享有關亞健康的癥狀,亞健康的治療方法,亞健康的預防知識,亞健康的癥狀圖片,亞健康吃什么藥,亞健康怎么治...
-
疰夏
628健康網為您分享有關疰夏的癥狀,疰夏的治療方法,疰夏的預防知識,疰夏的癥狀圖片,疰夏吃什么藥,疰夏怎么治療,疰夏患者食...
-
原發性甲狀旁腺功能亢進癥
628健康網為您分享有關原發性甲狀旁腺功能亢進癥的癥狀,原發性甲狀旁腺功能亢進癥的治療方法,原發性甲狀旁腺功能亢進癥...
-
呼吸暫停綜合癥
628健康網為您分享有關呼吸暫停綜合癥的癥狀,呼吸暫停綜合癥的治療方法,呼吸暫停綜合癥的預防知識,呼吸暫停綜合癥的癥狀...
-
自主性高功能性甲狀腺腺瘤
628健康網為您分享有關自主性高功能性甲狀腺腺瘤的癥狀,自主性高功能性甲狀腺腺瘤的治療方法,自主性高功能性甲狀腺腺瘤...
-
壯熱
628健康網為您分享有關壯熱的癥狀,壯熱的治療方法,壯熱的預防知識,壯熱的癥狀圖片,壯熱吃什么藥,壯熱怎么治療,壯熱患者食...
-
狐臭
628健康網為您分享有關狐臭的癥狀,狐臭的治療方法,狐臭的預防知識,狐臭的癥狀圖片,狐臭吃什么藥,狐臭怎么治療,狐臭患者食...
-
萎縮性鼻炎
628健康網為您分享有關萎縮性鼻炎的癥狀,萎縮性鼻炎的治療方法,萎縮性鼻炎的預防知識,萎縮性鼻炎的癥狀圖片,萎縮性鼻炎...
-
陰莖癌
628健康網為您分享有關陰莖癌的癥狀,陰莖癌的治療方法,陰莖癌的預防知識,陰莖癌的癥狀圖片,陰莖癌吃什么藥,陰莖癌怎么治...
-
慢性鼻炎
628健康網為您分享有關慢性鼻炎的癥狀,慢性鼻炎的治療方法,慢性鼻炎的預防知識,慢性鼻炎的癥狀圖片,慢性鼻炎吃什么藥,慢...
-
銀屑病
628健康網為您分享有關銀屑病的癥狀,銀屑病的治療方法,銀屑病的預防知識,銀屑病的癥狀圖片,銀屑病吃什么藥,銀屑病怎么治...
-
神經性皮炎
628健康網為您分享有關神經性皮炎的癥狀,神經性皮炎的治療方法,神經性皮炎的預防知識,神經性皮炎的癥狀圖片,神經性皮炎...
-
斑禿
628健康網為您分享有關斑禿的癥狀,斑禿的治療方法,斑禿的預防知識,斑禿的癥狀圖片,斑禿吃什么藥,斑禿怎么治療,斑禿患者食...
-
情感障礙
628健康網為您分享有關情感障礙的癥狀,情感障礙的治療方法,情感障礙的預防知識,情感障礙的癥狀圖片,情感障礙吃什么藥,情...
-
急性鼻炎
628健康網為您分享有關急性鼻炎的癥狀,急性鼻炎的治療方法,急性鼻炎的預防知識,急性鼻炎的癥狀圖片,急性鼻炎吃什么藥,急...
-
膽囊類癌
628健康網為您分享有關膽囊類癌的癥狀,膽囊類癌的治療方法,膽囊類癌的預防知識,膽囊類癌的癥狀圖片,膽囊類癌吃什么藥,膽...
-
胰腺異位
628健康網為您分享有關胰腺異位的癥狀,胰腺異位的治療方法,胰腺異位的預防知識,胰腺異位的癥狀圖片,胰腺異位吃什么藥,胰...
-
神經內分泌腫瘤皮膚轉移
628健康網為您分享有關神經內分泌腫瘤皮膚轉移的癥狀,神經內分泌腫瘤皮膚轉移的治療方法,神經內分泌腫瘤皮膚轉移的預防...
-
小兒肥胖
628健康網為您分享有關小兒肥胖的癥狀,小兒肥胖的治療方法,小兒肥胖的預防知識,小兒肥胖的癥狀圖片,小兒肥胖吃什么藥,小...
-
單純性乳腺增生癥
628健康網為您分享有關單純性乳腺增生癥的癥狀,單純性乳腺增生癥的治療方法,單純性乳腺增生癥的預防知識,單純性乳腺增生...
-
陰道白斑
628健康網為您分享有關陰道白斑的癥狀,陰道白斑的治療方法,陰道白斑的預防知識,陰道白斑的癥狀圖片,陰道白斑吃什么藥,陰...
-
滋養細胞腫瘤
628健康網為您分享有關滋養細胞腫瘤的癥狀,滋養細胞腫瘤的治療方法,滋養細胞腫瘤的預防知識,滋養細胞腫瘤的癥狀圖片,滋...